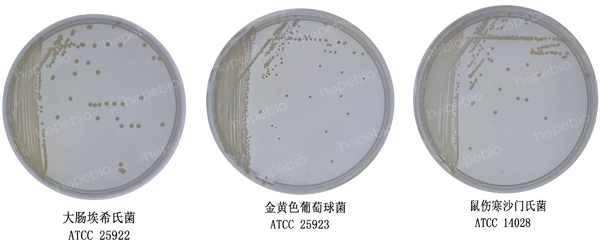

海博微信公众号
海博微信公众号
 海博天猫旗舰店
海博天猫旗舰店


 海博微信公众号
海博微信公众号
 海博天猫旗舰店
海博天猫旗舰店




一、产品用途及原理:
原理:酪蛋白胨、明胶胨提供氮源、碳源、维生素和生长因子;氯化钠维持渗透压;琼脂是培养基的凝固剂。
二、培养基配方(g/L):
|
酪蛋白胨 |
7.5 |
|
明胶胨 |
7.5 |
|
氯化钠 |
5.0 |
|
琼脂 |
15.0 |
|
pH值7.5±0.1(25℃) |
|
三、试验方法:
1、称取本品35.0g,加热煮沸溶解于1000mL蒸馏水中,分装,121℃高压灭菌15min,冷却至50℃左右时,倾入无菌平皿中备用。
2、制备质控菌株菌悬液,接种于培养基上。
3、放置于36℃±1℃需氧培养24h,观察试验结果。
四、试验结果判断:
接种以下质控菌株,放置于36℃±1℃需氧培养24h。结果如图1。
|
质控菌株 |
菌株编号 |
方法 |
生长情况 |
其他特征 |
|
大肠埃希氏菌 |
ATCC 25922 |
定性 |
+++ |
无色菌落 |
|
金黄色葡萄球菌 |
ATCC 25923 |
定性 |
+++ |
无色菌落 |
|
鼠伤寒沙门氏菌 |
ATCC 14028 |
定性 |
+++ |
无色菌落 |
图1 非乳酸菌选择性培养基微生物质控结果
相关产品:
注:本文属海博生物原创,未经允许不得转载。
下一篇:没有了!
| 相关文章: |



